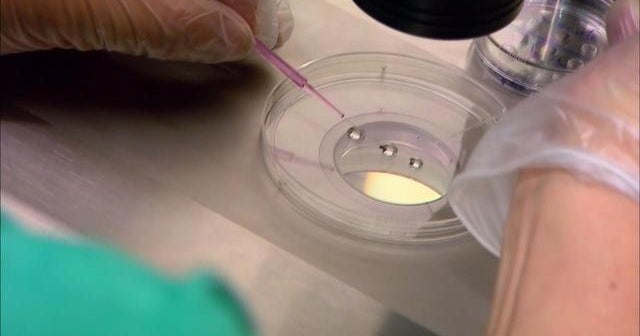
Fertility clinic hosts egg freezing party

Hence then, the article about fertility clinic hosts egg freezing party was published today ( ) and is available on CBS News ( Middle East ) The editorial team at PressBee has edited and verified it, and it may have been modified, fully republished, or quoted. You can read and follow the updates of this news or article from its original source.
Read More Details
Finally We wish PressBee provided you with enough information of ( Fertility clinic hosts egg freezing party )
Last updated :
Also on site :
- The unspoken financial strains breaking up friendships and how to navigate them
- New blood test could reveal if prostate cancer treatment is failing
- Alabama man goes through Walmart self-checkout. Then he uses a scanning trick to dramatically alter the price